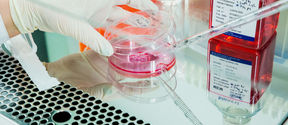
Laboratory work

Henkilöstöpalvelut - Sähkötekniikan korkeakoulu
Henkilöstöpalveluiden yhteystiedot Sähkötekniikan korkeakoulu (HR-palvelut)
Aallon kuuden koulun yhteinen HR-palvelupiste palvelee Aallon henkilöstöä seuraavissa asioissa:
Muista ottaa mukaan henkilöllisyystodistus kun asioit palvelupisteellä.
Muissa, kuin yllä mainituissa asioissa, palvelevat koulujen HR-tiimit, joiden yhteystiedot löydät tältä sivulta.
Aukiolo: tiistai ja keskiviikko klo 12-15. Kesällä palvelupiste on suljettuna 25.6 - 10.8.2026 välisen ajan.
Yhteystiedot: Kandikeskus, Otakaari 1, huone Y195
Poikkeusaikataulu: Palvelupiste on suljettuna 25.6 - 10.8 välisen ajan. Avaamme ovet kesän jälkeen ti 11.8 klo 12:00.

Henkilöstöpalveluiden yhteystiedot Sähkötekniikan korkeakoulu (HR-palvelut)
Henkilöstöpalveluiden yhteystiedot Kemian tekniikan korkeakoulussa (HR-palvelut).

Henkilöstöpalveluiden yhteystiedot Insinööritieteiden korkeakoulussa (HR-palvelut).

Henkilöstöpalveluiden yhteystiedot Perustieteiden korkeakoulu ja palkkatiimi (HR-palvelut).

Yhdessä Aalto-yliopiston HR-palveluiden kanssa Kauppakorkeakoulun HR-tiimi tukee koulun laitoksia ja yksiköitä kaikissa henkilöstöhallintoon liittyvissä asioissa. Olethan meihin yhteydessä, jos sinulla on kysyttävää. Autamme itse tai ohjaamme sinut eteenpäin.

Henkilöstöpalveluiden yhteystiedot Taiteiden ja suunnittelun korkeakoulu ARTS HR (HR-palvelut).

Henkilöstöpalveluiden yhteystiedot yliopiston yhteisissä palveluyksiköissä
Yleiset palvelut keskittyvät koko yliopiston HR-prosessien kehittämiseen ja hoitamiseen yleisellä tasolla. Otathan ensisijaisesti aina yhteyttä omia työsuhdeasiotasi hoitavaan lähi-HR yksikköösi.